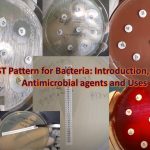
AST Pattern for Bacteria-Introduction, List of Antimicrobial agents and Uses

Tag: Proteus
PDA Test: Introduction, Principle, Test Requirements, Procedure, Result Interpretation, Keynotes and Limitations
 PDA Test PDA stands for phenylalanine deaminase and PDA test...
PDA Test PDA stands for phenylalanine deaminase and PDA test...
AST Pattern for Bacteria: Introduction, List of Antimicrobial agents and Uses
AST Pattern for Bacteria AST: Antimicrobial Sensitivity Testing Since not...
AST Pattern for Bacteria AST: Antimicrobial Sensitivity Testing Since not...
